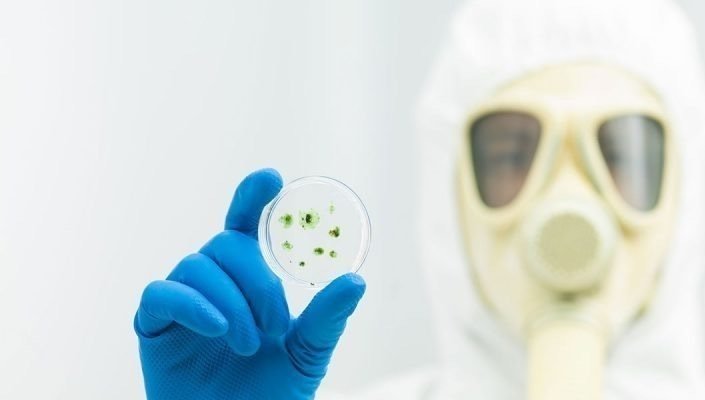

Toxic Black Mold Awareness

Toxic Black Mold Awareness
The Issue
This is a petition to bring awareness to the effects of Toxic Black Mold as well as Landlords’/Apartment complexes negligence and unprofessionalism in getting rid of and preventing Toxic Black Mold from destroying people’s livelihood while holding them responsible.
The Molds that were found in Apt 1522 consists of Aspergillus, Penicillium, Cladosporium, and Alternaria. These molds produce mycotoxins in the body that spread to every area that blood travels to. The mold spores of Aspergillus and Penicillium can get into your body through your eyes as well as lungs. THE MYCOTOXINS WILL CAUSE IRREVERSIBLE DAMAGE TO YOUR HEALTH. MOLD DOESN’T WAIT AND YOU SHOULDN’T EITHER. IF YOU LIVE IN THE MILL CREEK COMPLEX, YOU ARE AT RISK.
IF YOU OR SOMEONE YOU KNOW IN THE MILL CREEK AT WINDEMERE APARTMENT COMPLEX HAS OR HAS HAD WATER DAMAGE/TOXIC MOLD OR SUBSTANDARD LIVING CONDITIONS IN THEIR APARTMENT PLEASE DON’T HESITATE TO CONTACT ME AT 4082204154 TO GET YOUR STORY HEARD. PLEASE TEXT ME WITH ANY INFORMATION THAT CAN HELP INCLUDING YOUR HEALTH SINCE MOVING IN, NEGLIGENCE OF THE MILL CREEK STAFF, THE STAFF BLAMING AN APARTMENT ISSUE ON YOU AND TRYING TO GET YOU TO PAY FOR IT, THEIR NEGLIGENCE IN HELPING SOLVE THE PROBLEMS YOU MAY BE EXPERIENCING THAT’S THEIR FAULT, ETC.
IF YOU ARE WILLING TO JOIN THE LAWSUIT PLEASE CONTACT ME.
Please share with your family, friends and coworkers to spread awareness and sign even if none of this applies to them. Thank you.
My fiancé and I moved into 1522 Waterstone Place San Ramon, CA 94582 at Mill Creek at Windemere Apartments on October 21, 2022. It was our first apartment together and we were excited. Before moving in, we were told that the apartment was inspected prior to coming off a two week cruise. We didn’t have the time to walk through. First night we got there, we noticed black mold around the tub enclosure as well as in the holes in the caulking. We complained to management, and took all pictures for documentation. A week later nothing was done, so I caulked the tub enclosure so the scent and mold spores wouldn’t escape and get into our bodies. We both get sick November 11, 2022 for a week straight. Got tested for Covid, it wasn’t Covid. We then complained to Mill Creek and still nothing was done. Meanwhile, the toxic black mold is slowly making us sicker by the day. On December 2, 2022 they finally send an “inspector” that didn’t even want to poke a hole through the caulking to check for black mold until we insisted. She then concluded nothing was found but then we were put in a hotel December 10, 2022. During our stay in the hotel, we asked for updates while expressing our concerns of our deteriorating health and they kept dodging our detailed questions and cherry-picking what to answer. December 21, 2022 was the last day they scheduled our hotel for, which was pushed back twice prior. It couldn’t possibly take 10 days to replace a bathtub and enclosure. They then stated in email that nothing was found. They showed no evidence nothing was found and have yet to show us the record of the inspection. I write this on January 30, 2023, nothing else has been done concerning the black mold, mold spores in the air, on our clothes, on our furniture, in our food and now taking residence in our bodies. The pain is excruciating and numbing. The short and long term effects of this varies with a wide range. The symptoms include: kidney toxicity, immune system suppression, neurotoxicity, depression, chronic fatigue syndrome, cancer, acute pulmonary hemorrhage, aplastic anemia, birth defects, miscarriages, “ice pick” or “lightning bolt” pains, supplement sensitivities food sensitivities like salicylate intolerance, dry eyes, blurred vision, difficulty regulating body temperature, a higher number of static shocks, muscle cramps from electrolyte, disturbances, digestive issues, joint pain, cognitive issues, mood swings, numbness and tingling, inability to detox, weakened immune system, catching every infection, slow or difficulty healing, respiratory issues like sinusitis, bronchitis, coughs, aggravation of asthma, neurological issues like sleep problems, brain fog, headaches, fatigue, nausea, gastroesophageal reflux disease, esophagitis, vomiting, bleeding in the lungs and nose, chest tightness, skin rashes, dementia, hallucinations, ringing ears, irregular heartbeats, memory loss, speech problems, unexplained hot pain in localized body areas such as neck, shoulders and limbs. The list continues. My fiancé and I have been experiencing some of these.
As you can imagine, these symptoms are not to be taken lightly and should be avoided at all costs. Moreover, California Civil Code §§ 1941.1, 1941.3 and California Health and Safety Code § 17920.3 further elucidate a landlords requirements and standards they are to set in order to rent their properties. Other codes and laws exist to protect tenants that they are unaware of. My father always said “prevention is better than cure”. It’s also easier to get sick than healthy.
Please help spread awareness by sharing this petition and standing up to landlords and their negligence to maintain standard living for tenants and take accountability for their tenants livelihood.
My wife and I are not the only ones in the apartment complex that have complained, had symptoms, or have had to deal with the managements negligence. I’ve spoken to multiple tenants that have also complained of mold, water damage, pests, bugs, electrical issues etc. You are not alone. Don’t listen to the managements lies. They will put their profits over your health and gaslight you.
Also if you’ve made it this far, I have knowledge of supplements and liquids that will rid your body of mycotoxins.

180
The Issue
This is a petition to bring awareness to the effects of Toxic Black Mold as well as Landlords’/Apartment complexes negligence and unprofessionalism in getting rid of and preventing Toxic Black Mold from destroying people’s livelihood while holding them responsible.
The Molds that were found in Apt 1522 consists of Aspergillus, Penicillium, Cladosporium, and Alternaria. These molds produce mycotoxins in the body that spread to every area that blood travels to. The mold spores of Aspergillus and Penicillium can get into your body through your eyes as well as lungs. THE MYCOTOXINS WILL CAUSE IRREVERSIBLE DAMAGE TO YOUR HEALTH. MOLD DOESN’T WAIT AND YOU SHOULDN’T EITHER. IF YOU LIVE IN THE MILL CREEK COMPLEX, YOU ARE AT RISK.
IF YOU OR SOMEONE YOU KNOW IN THE MILL CREEK AT WINDEMERE APARTMENT COMPLEX HAS OR HAS HAD WATER DAMAGE/TOXIC MOLD OR SUBSTANDARD LIVING CONDITIONS IN THEIR APARTMENT PLEASE DON’T HESITATE TO CONTACT ME AT 4082204154 TO GET YOUR STORY HEARD. PLEASE TEXT ME WITH ANY INFORMATION THAT CAN HELP INCLUDING YOUR HEALTH SINCE MOVING IN, NEGLIGENCE OF THE MILL CREEK STAFF, THE STAFF BLAMING AN APARTMENT ISSUE ON YOU AND TRYING TO GET YOU TO PAY FOR IT, THEIR NEGLIGENCE IN HELPING SOLVE THE PROBLEMS YOU MAY BE EXPERIENCING THAT’S THEIR FAULT, ETC.
IF YOU ARE WILLING TO JOIN THE LAWSUIT PLEASE CONTACT ME.
Please share with your family, friends and coworkers to spread awareness and sign even if none of this applies to them. Thank you.
My fiancé and I moved into 1522 Waterstone Place San Ramon, CA 94582 at Mill Creek at Windemere Apartments on October 21, 2022. It was our first apartment together and we were excited. Before moving in, we were told that the apartment was inspected prior to coming off a two week cruise. We didn’t have the time to walk through. First night we got there, we noticed black mold around the tub enclosure as well as in the holes in the caulking. We complained to management, and took all pictures for documentation. A week later nothing was done, so I caulked the tub enclosure so the scent and mold spores wouldn’t escape and get into our bodies. We both get sick November 11, 2022 for a week straight. Got tested for Covid, it wasn’t Covid. We then complained to Mill Creek and still nothing was done. Meanwhile, the toxic black mold is slowly making us sicker by the day. On December 2, 2022 they finally send an “inspector” that didn’t even want to poke a hole through the caulking to check for black mold until we insisted. She then concluded nothing was found but then we were put in a hotel December 10, 2022. During our stay in the hotel, we asked for updates while expressing our concerns of our deteriorating health and they kept dodging our detailed questions and cherry-picking what to answer. December 21, 2022 was the last day they scheduled our hotel for, which was pushed back twice prior. It couldn’t possibly take 10 days to replace a bathtub and enclosure. They then stated in email that nothing was found. They showed no evidence nothing was found and have yet to show us the record of the inspection. I write this on January 30, 2023, nothing else has been done concerning the black mold, mold spores in the air, on our clothes, on our furniture, in our food and now taking residence in our bodies. The pain is excruciating and numbing. The short and long term effects of this varies with a wide range. The symptoms include: kidney toxicity, immune system suppression, neurotoxicity, depression, chronic fatigue syndrome, cancer, acute pulmonary hemorrhage, aplastic anemia, birth defects, miscarriages, “ice pick” or “lightning bolt” pains, supplement sensitivities food sensitivities like salicylate intolerance, dry eyes, blurred vision, difficulty regulating body temperature, a higher number of static shocks, muscle cramps from electrolyte, disturbances, digestive issues, joint pain, cognitive issues, mood swings, numbness and tingling, inability to detox, weakened immune system, catching every infection, slow or difficulty healing, respiratory issues like sinusitis, bronchitis, coughs, aggravation of asthma, neurological issues like sleep problems, brain fog, headaches, fatigue, nausea, gastroesophageal reflux disease, esophagitis, vomiting, bleeding in the lungs and nose, chest tightness, skin rashes, dementia, hallucinations, ringing ears, irregular heartbeats, memory loss, speech problems, unexplained hot pain in localized body areas such as neck, shoulders and limbs. The list continues. My fiancé and I have been experiencing some of these.
As you can imagine, these symptoms are not to be taken lightly and should be avoided at all costs. Moreover, California Civil Code §§ 1941.1, 1941.3 and California Health and Safety Code § 17920.3 further elucidate a landlords requirements and standards they are to set in order to rent their properties. Other codes and laws exist to protect tenants that they are unaware of. My father always said “prevention is better than cure”. It’s also easier to get sick than healthy.
Please help spread awareness by sharing this petition and standing up to landlords and their negligence to maintain standard living for tenants and take accountability for their tenants livelihood.
My wife and I are not the only ones in the apartment complex that have complained, had symptoms, or have had to deal with the managements negligence. I’ve spoken to multiple tenants that have also complained of mold, water damage, pests, bugs, electrical issues etc. You are not alone. Don’t listen to the managements lies. They will put their profits over your health and gaslight you.
Also if you’ve made it this far, I have knowledge of supplements and liquids that will rid your body of mycotoxins.

180
Petition Updates
Share this petition
Petition created on February 3, 2023